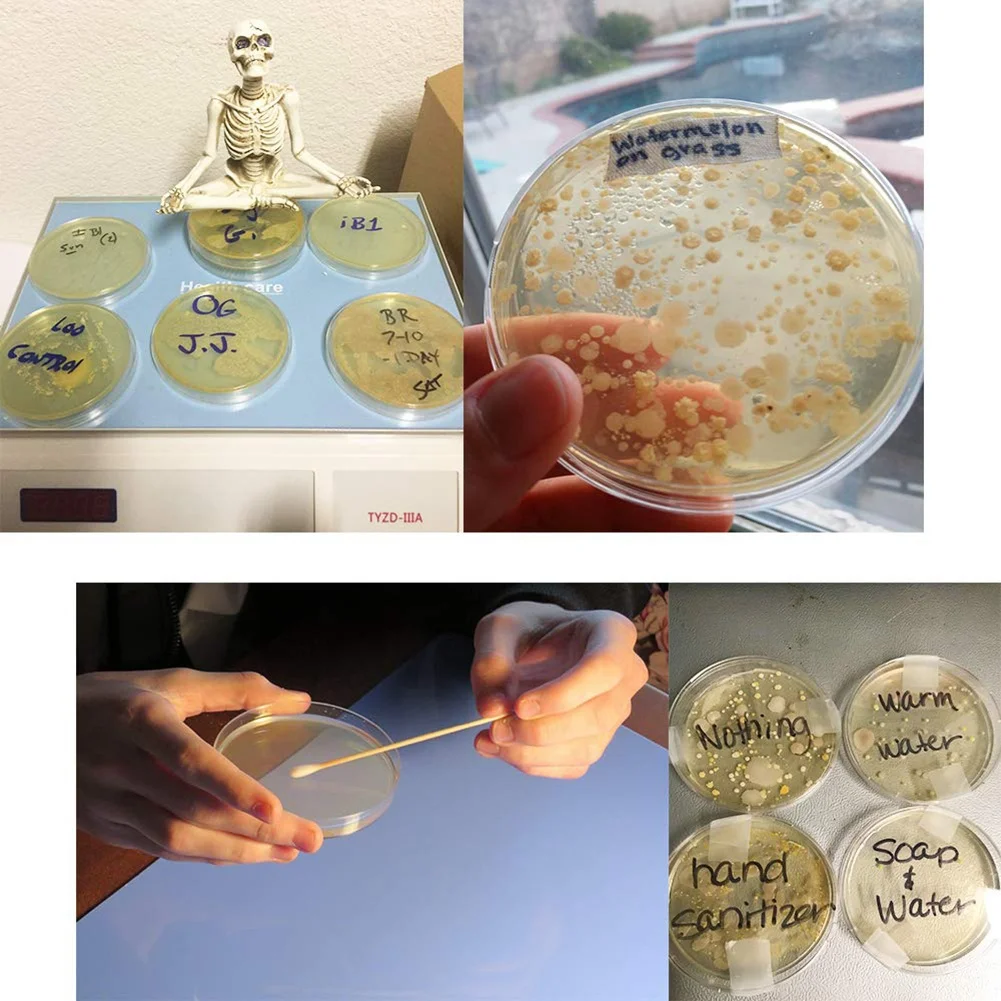
thumb

30 упаковок пластиковых чашек Петри, 90 х15 мм Прозрачные чашечки Петри с крышками, набор тарелок для культуры для научных проектов, школьная лаборатория
График изменения цены & курс обмена валют
Пользователи также просматривали

$3.07
Premium Gorgeous Vintage Double Ring Display Holder with Detachable Lid for Prop Dropship
aliexpress.ru
$8.60
30 Pcs Label Bag Bookmark Markers Holder Photo Sleeves Pvc Decorative DIY Accessory
aliexpress.ru
$2.40
Автомобильная розетка, ароматерапия, камелия, ромашка, лотос, аксессуар, силиконовая форма, подвеска
aliexpress.ru
$4.04
Искусственная Малина Реалистичная Малина модель искусственных фруктов поддельные растения фотография Реквизит корзина дисплей кухонный декор черный
aliexpress.ru
$19.54
Пустые фотообои с верхом для бака, Набор наклеек, одноразовая бумажная коробка, пластиковый контейнер с индивидуальным логотипом, 0,8 мл/1 мл
aliexpress.ru
$111.07
Автомобильная наклейка для кузова Ford Ranger, модификация внешней части, индивидуальная наклейка для внедорожника, спорта, аксессуары
aliexpress.ru
$560.00
Изготовленные на заказ Cnc фрезерные металлические алюминиевые детали Oem Cnc фрезерные услуги
aliexpress.ru
$22.43
Гипоаллергенные кубинские панцирные цепи PandaHall из нержавеющей стали 304, 33 фута (10 метров), незаваренные рулоны для изготовления ювелирных изделий своими руками
aliexpress.ru
$24.28
Контрастная Мужская футболка NOYMEI с коротким рукавом и плечевым ремнем, нестандартный дизайн, Новинка лета 2024, модный темпераментный Топ, WA4599
aliexpress.ru
$27.63
Кухонная подвесная стойка-органайзер с крючками, под шкаф, бумажное полотенце, вешалка для тряпок, разделочная доска, держатель для крышки кастрюли, полка для хранения
aliexpress.ru
$16.49
Автомобильный Новый воздушно-топливный кислородный O2 лямбда-датчик 89465-50120 для Toyota 4runner FJ Cruiser Lexus GS430 LS430 SC430 GX470 234-4138
aliexpress.ru
$17.28
Женский браслет из тонкой золотой нитки, розовый нефритовый браслет, Фиолетовый нефритовый браслет
aliexpress.ru
$10.67
Пазл тишина истребители Персонализированная игрушка настраиваемый подарок для детей деревянные взрослые игрушки для детей пазл
aliexpress.ru
$12.28
31689103 крепежная лента на петлю передней двери, подставка для двери для Volvo S90 V90 2018 2019 2020 2021 2022 2023, автомобильные аксессуары
aliexpress.ru
$15.55
Дневной журнал, блокнот, записная книжка, планировщик, личный дневник, органайзер с замком, портативные канцелярские принадлежности для дома, офиса, школы
aliexpress.ru
$18.34
Рыболовная катушка HE500, спиннинговая катушка с максимальным усилием тяги 10 кг, 5,2: 1, высокоскоростная металлическая катушка, стандартная катушка, рыболовные принадлежности
aliexpress.ru
$25.94
Резервуар для воды для Roborock S8 S8 Pro Ultra S8 + быстрозаменяемый резервуар для сточных вод
aliexpress.ru
$7.05
Outdoor Camping Canopy Pole Holder Bracket Fixed Pipe Rack Support Pole Tent Accessories For Travel Home
aliexpress.com
$49.85
Radiator Guard Cover Protector Grille FOR 300 XC-W 450 EXC-F TPI SIX DAYS 2019 450 EXC-F Accessories Radiator Guards Oil Cooler
aliexpress.com
$19.27
Baroque Style Leggings Sexy Dahlia Flowers Print Workout Yoga Pants Push Up Elastic Sports Tights Funny Custom Leggins Gift Idea
aliexpress.com
$62.30
For Toyota Alphard Vellfire 30 Series 2015-2023 2022 2021 Upgraded Accessories Trunk Tailgate Warning Light Door Reading Lamp
aliexpress.com
$11.04
Summer Women Denim Jeans Shorts Preppy Style High Waist Short Wide Leg Pants Braces Strap Suspender Pants Trousers Rompers 2XL
aliexpress.com
$14.39
Popular Anime Himiko Toga 3D Hoodies New My Hero Academia Hoodie Cute Toga Himiko Coats Boys/girls Hip Hop 3D Printed Clothes
aliexpress.com
$45.95
22In Looking Lifelike Realistic Baby Newborn Care Easy Open Eyes Toywith Yellow Clothes for Children and the Elderly
aliexpress.com
$16.25
White Noise Machine USB Rechargeable Timed Shutdown Sleep Sound Machine For Sleeping & Relaxation For Baby Adult Office Travel
aliexpress.com
$4.85
The New Bicycle Widens And Comfortable Sponge Cushion Mountain Bike Safe And Comfortable Sponge Cushion Riding Equipment
aliexpress.com
$7.19
2PCS Carbon Fiber 9450S Propeller Self Locking Blades For DJI Phantom 4 Drone Spare Parts Props Accessories with Props Base
aliexpress.com
$19.60
Women Party Dress Sexy Black Long Sleeve Deep V Side Slit Long Dresses Womens Elegant dress
aliexpress.com
$21.36
women quick dry sport shirt,professional short sleeve breathable exercises yoga t-shirts for gym running fitness, White;red
dhgate.com